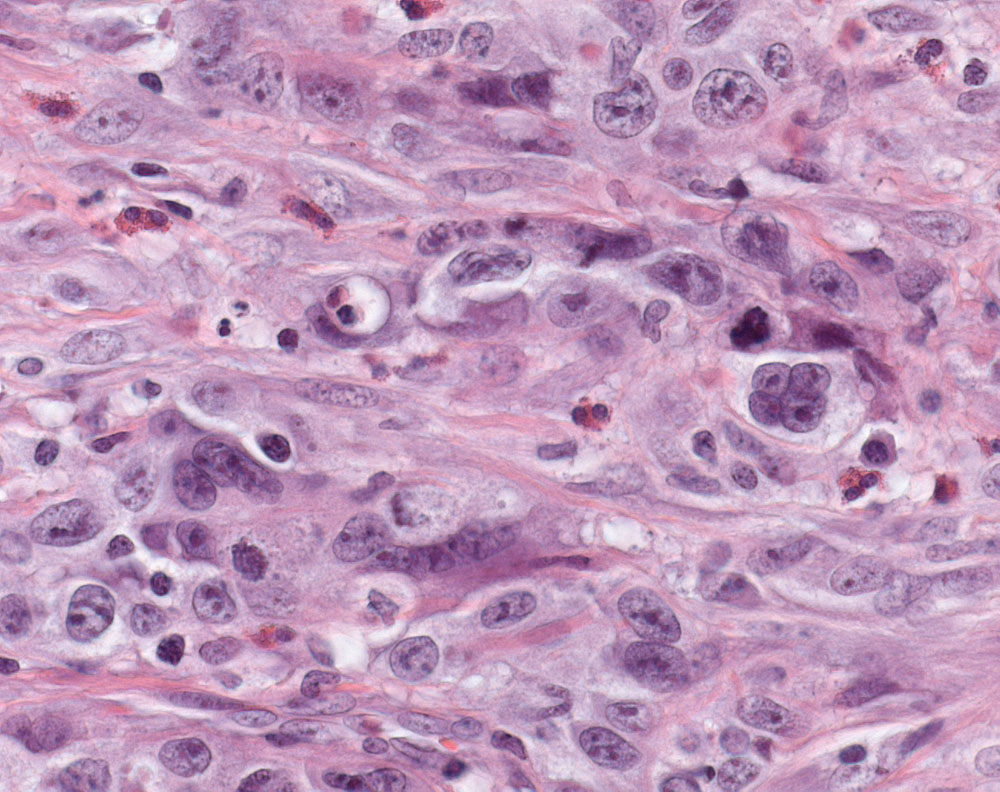

Abarema gallorum est une espèce de plantes à fleurs de la famille des Fabaceae.
Selon Plants of the World Online, c'est un synonyme de Jupunba gallorum. Selon ce site, c'est un arbre trouvé en Guyane.
Description
C'est un arbre.
Répartition
L'espèce est trouvée en Guyane.
Notes et références
Liens externes
- (en) JSTOR Plants : Abarema gallorum (consulté le )
- (en) The Plant List : Abarema gallorum Barneby & J.W.Grimes (source : The International Legume Database and Information Service ou ILDIS) (consulté le )
- (en) Tropicos : Abarema gallorum Barneby & J.W. Grimes ( liste sous-taxons) (consulté le )
- (fr) INPN : Jupunba gallorum (TAXREF) (consulté le )
- Portail des Fabaceae
- Portail de la Guyane